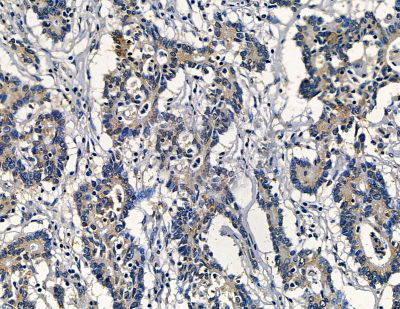
product-image-AAA330087_IHC15.jpg

Mouse Laminin 2 alpha Monoclonal Antibody | anti-LAMA2 antibody
Laminin 2 alpha Mouse Monoclonal Antibody
Prediction: Pig, Bovine, Horse, Sheep, Rabbit, Dog
Prediction: Pig, Bovine, Horse, Sheep, Rabbit, Dog
IF (Immunofluorescence)
(AAA330087 staining HepG2 cells by IF/ICC. The samples were fixed with PFA and permeabilized in 0.1% Triton X-100, then blocked in 10% serum for 45 minutes at 25 degree C. Samples were then incubated with primary Ab(#AAA330087) and rabbit anti-beta tubulin Ab for 1 hour at 37 degree C. An AlexaFluor594 conjugated goat anti-mouse IgG Ab(Red) and an AlexaFluor488 conjugated goat anti-rabbit IgG Ab(Green) were used as the secondary antibody. The nuclear counter stain is DAPI (blue).)
IHC (Immunohistochemisry)
(AAA330087 at 1/100 staining mouse liver tissue by IHC-P. The sample was formaldehyde fixed and a heat mediated antigen retrieval step in citrate buffer was performed. The sample was then blocked and incubated with the primary antibody at 4 degree C overnight. An HRP conjugated anti-mouse antibody was used as the secondary antibody.)
IHC (Immunohiostchemistry)
(AAA330087 at 1/100 staining mouse heart tissue by IHC-P. The sample was formaldehyde fixed and a heat mediated antigen retrieval step in citrate buffer was performed. The sample was then blocked and incubated with the primary antibody at 4 degree C overnight. An HRP conjugated anti-mouse antibody was used as the secondary antibody.)
IHC (Immunohistochemistry)
(AAA330087 at 1/100 staining human prostate cancer by IHC-P. The sample was formaldehyde fixed and a heat mediated antigen retrieval step in citrate buffer was performed. The sample was then blocked and incubated with the primary antibody at 4 degree C overnight. An HRP conjugated anti-mouse antibody was used as the secondary antibody.)
NCBI and Uniprot Product Information
Customer Reviews
Loading reviews...
Share Your Experience
Similar Products
Product Notes
The LAMA2 (Catalog #AAA330087) is an Antibody produced from Mouse and is intended for research purposes only. The product is available for immediate purchase. The Laminin 2 alpha Mouse Monoclonal Antibody reacts with Human, Mouse, Rat Prediction: Pig, Bovine, Horse, Sheep, Rabbit, Dog and may cross-react with other species as described in the data sheet. AAA Biotech's Laminin 2 alpha can be used in a range of immunoassay formats including, but not limited to, ICC (Immunocytochemistry), IF (Immunofluorescence), IHC (Immunohistochemistry). Researchers should empirically determine the suitability of the LAMA2 for an application not listed in the data sheet. Researchers commonly develop new applications and it is an integral, important part of the investigative research process. The amino acid sequence is listed below: MPGAAGVLLL LLLSGGLGGV QAQRPQQQRQ SQAHQQRGLF PAVLNLASNA LITTNATCGE KGPEMYCKLV EHVPGQPVRN PQCRICNQNS SNPNQRHPIT NAIDGKNTWW QSPSIKNGIE YHYVTITLDL QQVFQIAYVI VKAANSPRPG NWILERSLDD VEYKPWQYHA VTDTECLTLY NIYPRTGPPS YAKDDEVICT SFYSKIHPLE NGEIHISLIN GRPSADDPSP ELLEFTSARY IRLRFQRIRT LNADLMMFAH KDPREIDPIV TRRYYYSVKD ISVGGMCICY GHARACPLDP ATNKSRCECE HNTCGDSCDQ CCPGFHQKPW RAGTFLTKTE CEACNCHGKA EECYYDENVA RRNLSLNIRG KYIGGGVCIN CTQNTAGINC ETCTDGFFRP KGVSPNYPRP CQPCHCDPIG SLNEVCVKDE KHARRGLAPG SCHCKTGFGG VSCDRCARGY TGYPDCKACN CSGLGSKNED PCFGPCICKE NVEGGDCSRC KSGFFNLQED NWKGCDECFC SGVSNRCQSS YWTYGKIQDM SGWYLTDLPG RIRVAPQQDD LDSPQQISIS NAEARQALPH SYYWSAPAPY LGNKLPAVGG QLTFTISYDL EEEEEDTERV LQLMIILEGN DLSISTAQDE VYLHPSEEHT NVLLLKEESF TIHGTHFPVR RKEFMTVLAN LKRVLLQITY SFGMDAIFRL SSVNLESAVS YPTDGSIAAA VEVCQCPPGY TGSSCESCWP RHRRVNGTIF GGICEPCQCF GHAESCDDVT GECLNCKDHT GGPYCDKCLP GFYGEPTKGT SEDCQPCACP LNIPSNNFSP TCHLDRSLGL ICDGCPVGYT GPRCERCAEG YFGQPSVPGG SCQPCQCNDN LDFSIPGSCD SLSGSCLICK PGTTGRYCEL CADGYFGDAV DAKNCQPCRC NAGGSFSEVC HSQTGQCECR ANVQGQRCDK CKAGTFGLQS ARGCVPCNCN SFGSKSFDCE ESGQCWCQPG VTGKKCDRCA HGYFNFQEGG CTACECSHLG NNCDPKTGRC ICPPNTIGEK CSKCAPNTWG HSITTGCKAC NCSTVGSLDF QCNVNTGQCN CHPKFSGAKC TECSRGHWNY PRCNLCDCFL PGTDATTCDS ETKKCSCSDQ TGQCTCKVNV EGIHCDRCRP GKFGLDAKNP LGCSSCYCFG TTTQCSEAKG LIRTWVTLKA EQTILPLVDE ALQHTTTKGI VFQHPEIVAH MDLMREDLHL EPFYWKLPEQ FEGKKLMAYG GKLKYAIYFE AREETGFSTY NPQVIIRGGT PTHARIIVRH MAAPLIGQLT RHEIEMTEKE WKYYGDDPRV HRTVTREDFL DILYDIHYIL IKATYGNFMR QSRISEISME VAEQGRGTTM TPPADLIEKC DCPLGYSGLS CEACLPGFYR LRSQPGGRTP GPTLGTCVPC QCNGHSSLCD PETSICQNCQ HHTAGDFCER CALGYYGIVK GLPNDCQQCA CPLISSSNNF SPSCVAEGLD DYRCTACPRG YEGQYCERCA PGYTGSPGNP GGSCQECECD PYGSLPVPCD PVTGFCTCRP GATGRKCDGC KHWHAREGWE CVFCGDECTG LLLGDLARLE QMVMSINLTG PLPAPYKMLY GLENMTQELK HLLSPQRAPE RLIQLAEGNL NTLVTEMNEL LTRATKVTAD GEQTGQDAER TNTRAKSLGE FIKELARDAE AVNEKAIKLN ETLGTRDEAF ERNLEGLQKE IDQMIKELRR KNLETQKEIA EDELVAAEAL LKKVKKLFGE SRGENEEMEK DLREKLADYK NKVDDAWDLL REATDKIREA NRLFAVNQKN MTALEKKKEA VESGKRQIEN TLKEGNDILD EANRLADEIN SIIDYVEDIQ TKLPPMSEEL NDKIDDLSQE IKDRKLAEKV SQAESHAAQL NDSSAVLDGI LDEAKNISFN ATAAFKAYSN IKDYIDEAEK VAKEAKDLAH EATKLATGPR GLLKEDAKGC LQKSFRILNE AKKLANDVKE NEDHLNGLKT RIENADARNG DLLRTLNDTL GKLSAIPNDT AAKLQAVKDK ARQANDTAKD VLAQITELHQ NLDGLKKNYN KLADSVAKTN AVVKDPSKNK IIADADATVK NLEQEADRLI DKLKPIKELE DNLKKNISEI KELINQARKQ ANSIKVSVSS GGDCIRTYKP EIKKGSYNNI VVNVKTAVAD NLLFYLGSAK FIDFLAIEMR KGKVSFLWDV GSGVGRVEYP DLTIDDSYWY RIVASRTGRN GTISVRALDG PKASIVPSTH HSTSPPGYTI LDVDANAMLF VGGLTGKLKK ADAVRVITFT GCMGETYFDN KPIGLWNFRE KEGDCKGCTV SPQVEDSEGT IQFDGEGYAL VSRPIRWYPN ISTVMFKFRT FSSSALLMYL ATRDLRDFMS VELTDGHIKV SYDLGSGMAS VVSNQNHNDG KWKSFTLSRI QKQANISIVD IDTNQEENIA TSSSGNNFGL DLKADDKIYF GGLPTLRNLS MKARPEVNLK KYSGCLKDIE ISRTPYNILS SPDYVGVTKG CSLENVYTVS FPKPGFVELS PVPIDVGTEI NLSFSTKNES GIILLGSGGT PAPPRRKRRQ TGQAYYAILL NRGRLEVHLS TGARTMRKIV IRPEPNLFHD GREHSVHVER TRGIFTVQVD ENRRYMQNLT VEQPIEVKKL FVGGAPPEFQ PSPLRNIPPF EGCIWNLVIN SVPMDFARPV SFKNADIGRC AHQKLREDED GAAPAEIVIQ PEPVPTPAFP TPTPVLTHGP CAAESEPALL IGSKQFGLSR NSHIAIAFDD TKVKNRLTIE LEVRTEAESG LLFYMARINH ADFATVQLRN GLPYFSYDLG SGDTHTMIPT KINDGQWHKI KIMRSKQEGI LYVDGASNRT ISPKKADILD VVGMLYVGGL PINYTTRRIG PVTYSIDGCV RNLHMAEAPA DLEQPTSSFH VGTCFANAQR GTYFDGTGFA KAVGGFKVGL DLLVEFEFRT TTTTGVLLGI SSQKMDGMGI EMIDEKLMFH VDNGAGRFTA VYDAGVPGHL CDGQWHKVTA NKIKHRIELT VDGNQVEAQS PNPASTSADT NDPVFVGGFP DDLKQFGLTT SIPFRGCIRS LKLTKGTGKP LEVNFAKALE LRGVQPVSCP AN. It is sometimes possible for the material contained within the vial of "Laminin 2 alpha, Monoclonal Antibody" to become dispersed throughout the inside of the vial, particularly around the seal of said vial, during shipment and storage. We always suggest centrifuging these vials to consolidate all of the liquid away from the lid and to the bottom of the vial prior to opening. Please be advised that certain products may require dry ice for shipping and that, if this is the case, an additional dry ice fee may also be required.Precautions
All products in the AAA Biotech catalog are strictly for research-use only, and are absolutely not suitable for use in any sort of medical, therapeutic, prophylactic, in-vivo, or diagnostic capacity. By purchasing a product from AAA Biotech, you are explicitly certifying that said products will be properly tested and used in line with industry standard. AAA Biotech and its authorized distribution partners reserve the right to refuse to fulfill any order if we have any indication that a purchaser may be intending to use a product outside of our accepted criteria.Disclaimer
Though we do strive to guarantee the information represented in this datasheet, AAA Biotech cannot be held responsible for any oversights or imprecisions. AAA Biotech reserves the right to adjust any aspect of this datasheet at any time and without notice. It is the responsibility of the customer to inform AAA Biotech of any product performance issues observed or experienced within 30 days of receipt of said product. To see additional details on this or any of our other policies, please see our Terms & Conditions page.Item has been added to Shopping Cart
If you are ready to order, navigate to Shopping Cart and get ready to checkout.